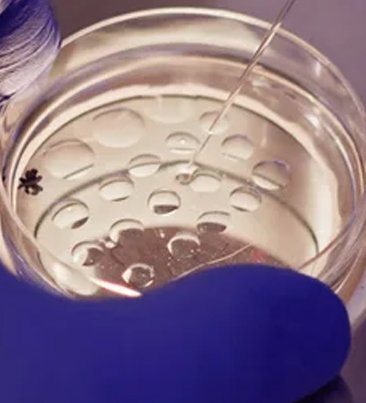

Surgical sperm retrieval is a process of sperm extraction from male patients who have sperm ejaculation issues and no sperm in the ejaculate. Surgical sperm retrieval procedure provides a chance to get their own child with IVF-ICSI process.
Aadhi fertility centre Hyderabad is equipped with a modern fertility laboratory and provides best solutions with all fertility treatment for male and female infertility couples. Fertility specialists in Uppal Hyderabad at Aadhi fertility centre are expertise in all surgical techniques for sperm retrieval in the infertile male.
Men with no sperm condition azoospermia, sperm blockage, low sperm count or in immotile sperm, or with abnormal sperm parameters can become father and have their own child with Aadhi fertility centre sperm retrieval treatment in Hyderabad.
Surgical sperm extraction is a fertility treatment procedure used to treat severe male infertility issues with various sperm retrieval techniques. The scientific extraction of sperm from semen will enhance the chances of having their own childs.
The surgical sperm retrieval success rate is high. The extracted fresh healthy sperm is used immediately or kept frozen for years for future fertility treatment. Intracytoplasmic sperm injection process is used to inject the extracted healthy sperm for IVF treatment.
Surgical Sperm Retrieval (SSR) is an advanced sperm extraction technique for collecting sperm directly from an infertile man who is having no sperm during their ejaculation. In these males, the sperm is collected scientifically using various sperm retrieval techniques from their testicles, epididymis or vas deferens.
There are many common issues seen in men which are involved in men infertility are erectile dysfunction, premature ejaculation, impotence, and problems with sperm quality, concentration and motility of the sperm. All these male infertility issues impact the couple’s parenthood dream directly.
In men, stress, work, life, and responsibilities, insufficient or imbalanced nutrition, poor lifestyle, smoking, drinking alcohol, lack of physical activity, injuries to testis, infections, diseases, certain medications and other health conditions are making the men a infertile.
Surgical sperm retrieval process can be a successful fertility treatment solution for male-factor infertility.
IVF is not just a medical procedure — it’s a journey filled with hope, resilience, and emotional strength. For many, it represents a second chance at building the family they’ve always dreamed of. With supportive care and advanced technology, IVF continues to be a beacon of possibility in the field of reproductive health.


IVF is not just a medical procedure — it’s a journey filled with hope, resilience, and emotional strength. For many, it represents a second chance at building the family they’ve always dreamed of. With supportive care and advanced technology, IVF continues to be a beacon of possibility in the field of reproductive health.
IVF is not just a medical procedure — it’s a journey filled with hope, resilience, and emotional strength. For many, it represents a second chance at building the family they’ve always dreamed of. With supportive care and advanced technology, IVF continues to be a beacon of possibility in the field of reproductive health.
In men, sperm can be extracted in many ways from their reproductive tract. Here are the types of surgical extraction procedures (SEps or SRPs) available for men. The goal of these SSR techniques is to extract the health quality sperm for fertilisation.
All these sperm retrieval procedures are performed with local anaesthesia. Sperm is collected from vas deferens, epididymis and testicles in the male reproductive tract.
At Aadhi fertility centre Uppal, the urologist and fertility specialists who are specialised and experienced in reproductive medicine and laparoscopic surgeries together finalise and recommend the best sperm retrieval method that is suitable for your particular reproductive and infertility condition.
Surgical Sperm Retrieval (SSR) techniques are most successful sperm extraction procedures for men with serious fertility issues especially no sperm or sperm ejaculate issues or blockage problems. Surgical Sperm Retrieval technique to select based on the sperm source in the reproductive tract and patient preference.
Aadhi fertility clinic Hyderabad is the best Surgical Sperm Retrieval clinic in Hyderabad nearby areas for highly standard fertility treatment services with accurate and evidence-based sperm freezing, testis tissues freezing, Embryo freezing, egg freezing, PCOS treatment, PCOD treatment, men and female infertility treatment, laparoscopic surgery in Hyderabad and Secunderabad. Aadhi fertility clinic with more than 70% to 80% success rate for IVF treatment and other fertility treatment procedures used to treat the male and female infertility, reproductive healthcare, reproductive medicine, personalised fertility care, infertility counselling and evaluation.
The staff, fertility specialists, urologist and gynaecologist, embryologists, laparoscopic surgeons, fertility doctors in Hyderabad nearby areas at Aadhi fertility centre Uppal are highly experienced and specialists in diverse reproductive treatments, ART techniques and infertility treatment options for men and women.
Call now Aadhi fertility clinic +91 8106506699 for male fertility treatment in Hyderabad and Telangana, Andhra Pradesh areas.

Aadhi Fertility Centre Hyderabad brings over 15 years of clinical experience in reproductive medicine, offering evidence-based care for couples facing male and female infertility. With a strong track record in IVF, IUI, ICSI, and advanced diagnostic evaluations, the centre follows standardised protocols, scientific methodology, safe procedures, transparent communication, and ethical practices to support patients at every stage of their fertility journey. Each inferility treatment plan is designed after a detailed assessment, ensuring the approach aligns with medical history, lifestyle factors, and individual reproductive needs.
Call now 8106506699, Aadhi fertility centre Hyderabad for male and female infertility treatment plans, IVF, IUI and ICSI, men and women reproductive healthcare.